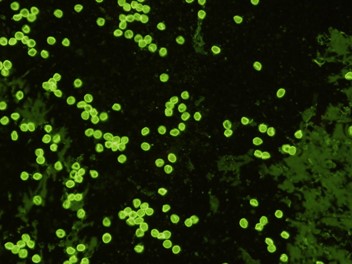

ViroStat, Inc.
![]() ViroStat社ホームページ |
ViroStat社(アメリカ)はウイルス学・細菌学・寄生虫学等の感染症関連のご研究に使用いただける抗体・抗原を製造しております。MONOTOPE™モノクローナル抗体・OMNITOPE™ポリクローナル抗体・リコンビナント抗原等500種類以上の感染症研究用試薬をご紹介します。 |
関連ページ:(株)東京未来スタイル取扱い 診断薬原料一覧
商品特集
鳥インフルエンザウイルスに対するモノクローナル抗体
Canine Coronavirusの抗体
グラム陰性菌の迅速な検出
尿から感染症を検査する
レプトスピラ(Leptospira)に対するモノクローナル抗体
クリプトスポリジウム(Cryptosporidium parvum)に対するモノクローナル抗体
犬ジステンパーウイルスに対するモノクローナル抗体
新型コロナウイルス感染症(COVID-19)関連商品 HOT
サンドイッチELISAのベストペア抗体
デングウイルスNS1 MAb
ジカウイルスNS1 MAb商品情報
新商品情報
2023/08/21
鳥インフルエンザウイルスに対するモノクローナル抗体
CDCは、H5N1 鳥インフルエンザが、国内の家禽類の群れだけでなく、野鳥のいくつかの種で発見された、と報告しました。このウイルスによる散発的な感染は、哺乳動物(キツネ、アライグマ、スカンク、ピューマ)でも発見されました。アメリカでは、感染した鳥による曝露のケースがありましたが、ヒト-ヒト感染は発生しませんでした。
ViroStat社のモノクローナル抗体は、高度に保存されたインフルエンザA型ウイルスの核タンパク質を標的とします。従って、これらモノクローナル抗体のペアは、ヒト、鳥類、ブタ、ウマの種で見つかった多くのインフルエンザA型の株を検出します。それらには、H1-H14型とN1-N9型のウイルスが含まれています。これら抗体ペアを利用する免疫アッセイは、人体内のインフルエンザA型ウイルスの発見と他の動物種における流行の監視に有用です。

| カタログ番号 | 特異性 | 宿主 | 単位 | データシート |
|---|---|---|---|---|
| 1331 | Influenza A – from A/Texas strain. | Mouse | 100 µg | Datasheet |
| 1341 | Influenza A – specific for nucleoprotein. | Mouse | 100 µg | |
| 1361 | Influenza A – specific for nucleoprotein. | Mouse | 100 µg | |
| 1371 | Influenza A – specific for nucleoprotein. | Mouse | 100 µg | |
| 1381 | Influenza A – specific for nucleoprotein. | Mouse | 100 µg | |
| 1385 | Influenza A – specific for nucleoprotein. | Mouse | 100 µg | |
| 1333 | Influenza A – from A/Texas strain. | Mouse | 100 µg | |
| 1343 | Influenza A – specific for nucleoprotein. | Mouse | 100 µg |
Canine Coronavirusの抗体
Canine Coronavirus(犬のコロナウイルス)は、犬において伝染性の強い胃腸管の感染症を引き起こします。Canine Coronavirusはアルファコロナウイルス1であるためヒトに感染せず、呼吸器症状も起こしません。このウイルスは糞便や汚染された餌から口を介して感染します。子犬は特に感染の影響を受けやすく、しばしば激しい下痢を起こします。
ViroStat社はCanine Coronavirusのモノクローナル抗体の販売を開始しました。これらの新たな抗体はCanine Coronavirusのヌクレオカプシドに特異的に結合し、他のCanine virusとは交差反応を起こしません。これらの抗体はウイルスの迅速測定のために、ペアの形態となっています。

| カタログ番号 | 特異性 | 宿主 | 単位 | データシート |
|---|---|---|---|---|
| 3881 | Canine Coronavirus | Mouse | 100 µg | Datasheet |
| 3882 | Canine Coronavirus | Mouse | 100 µg | |
| 3883 | Canine Coronavirus | Mouse | 100 µg |
グラム陰性菌の迅速な検出
グラム陰性菌は、尿路感染症や食中毒、腸チフス、敗血症を含む様々な病気を引き起こします。これらの細菌の多くは培養により検出されますが、この手法は労力と時間を要します。上記の感染症に対して早く正確に治療するためには、迅速な診断が肝要です。
ViroStat社はE. coliやサルモネラ菌、赤痢菌などを含むこれらの細菌の大半に共通して存在するLPSを検出するモノクローナル抗体ペアの販売を開始しました。これらの抗体は迅速かつ培養によらない免疫アッセイ(ELISAやイムノクロマトグラフィ)で直接これらの細菌を検出するのに有用です。

| カタログ番号 | 特異性 | 宿主 | 単位 | データシート |
|---|---|---|---|---|
| 1054 | Gram negative bacteria | Mouse | 100 µg | Datasheet |
| 1055 | Gram negative bacteria | Mouse | 100 µg |
尿から感染症を検査する
多くのヒトの感染症では、感染期間中に特定の抗原が尿中へと排出されます。これらの抗原はしばしばバクテリアや菌のLPSや細胞壁のポリサッカライドを元とするグリカンや炭水化物です。
尿は血液や組織の生検とは対照的に非侵襲的なので、標本として理想的です。
このような感染症の例
- ・肺炎(Streptococcus pneumoniae)
- ・レジオネラ症(Legionella pneumophila)
- ・結核(Mycobacterium species)
- ・アスペルギルス症(Aspergillus species)
Virostat社では、これらすべての病原体に特異的なウサギモノクローナル抗体をご用意しております。これらの抗体は検出用ペアやセルフペアとして抗原検出アッセイにご利用いただけます。全ての商品が体外診断用医薬品の原料としてご利用いただけます。

| カタログ番号 | 特異性 | 宿主 | 単位 | データシート |
|---|---|---|---|---|
| 0494 | Streptococcus pneumoniae CWPS | Rabbit | 100 µg | Datasheet |
| 0495 | Streptococcus pneumoniae CWPS | Rabbit | 100 µg | |
| 0435 | Group A Streptococcus | Rabbit | 100 µg | Datasheet |
| 1525 | Group B Streptococcus | Rabbit | 100 µg | Datasheet |
| 6026 | Legionella pneumophila serogroup 1 | Rabbit | 100 µg | Datasheet |
| 5179 | Mycobacteria LAM | Rabbit | 100 µg | Datasheet |
| 5180 | Mycobacteria LAM | Rabbit | 100 µg | |
| 5144 | Aspergillus species | Rabbit | 100 µg | Datasheet |
| 5145 | Aspergillus species | Rabbit | 100 µg | |
| 5146 | Aspergillus species | Rabbit | 100 µg |
レプトスピラ(Leptospira)に対するモノクローナル抗体
レプトスピラ(Leptospira)はらせん状の形態を持つバクテリアで、その内いくつかの種は感染症であるレプトスピラ症を引き起こす病原体となっています。犬やげっ歯類を含む動物は、感染した尿への接触を介してこの感染症をヒトに伝染させることがあります。レプトスピラは血流をめぐり、腎不全や肺の出血を引き起こします。推奨されている治療はドキシサイクリンの投与です。
L. interrogansやL. kirschneriなどの種を含む病原性のレプトスピラは、複数のマーカーによって病原性を持たない種と識別されます。その中でも主要なマーカーは外膜のリポタンパク質です。
ViroStat社はこのリポタンパク質LipL41に対するモノクローナル抗体を発売いたしました。LipL41は病原性のレプトスピラから大量に検出される細胞表面のリポタンパク質です。今回発売した抗体はELISAにおいてLipL41とペアを形成し、検出します。このため追加での免疫アッセイ検出に使用できる可能性があります。

| カタログ番号 | 特異性 | 宿主 | 単位 | データシート |
|---|---|---|---|---|
| 0411 | outer membrane lipoprotein LipL41 | Mouse | 100 µg | Datasheet |
| 0412 | outer membrane lipoprotein LipL41 | Mouse | 100 µg | |
| 0413 | outer membrane lipoprotein LipL41 | Mouse | 100 µg | |
| 0414 | outer membrane lipoprotein LipL41 | Mouse | 100 µg |
クリプトスポリジウム(Cryptosporidium parvum)に対するモノクローナル抗体
クリプトスポリジウム(Cryptosporidium parvum)は、世界中で下痢症の主要な原因となっている寄生虫です。この要因は大部分において、クリプトスポリジウムの感染性のオーシストが持つ環境への抵抗力にあります。クリプトスポリジウムのシストは、プールや排水の消毒に使用される通常の量の塩素に耐性があり、凍結やpHの変化にも耐性を持っています。感染は糞口経路を介して、シストが経口摂取されることで起こります。感染中は増殖したシストが糞便中に大量に排出されます。
ViroStat社はこのたび、クリプトスポリジウム(Cryptosporidium parvum)のオーシストに対応する2つの新しいウサギモノクローナル抗体(MabyRab™)を発売いたしました。MabyRab™はシストの細胞壁の糖鎖抗原に特異的です。これらの抗体はELISAにおいて、低レベルのシストを検出するペアを形成します。またこれらの抗体を用いて免疫蛍光法によりシストを染色することも検証済みです。
| カタログ番号 | 特異性 | 宿主 | 単位 | データシート |
|---|---|---|---|---|
| 7641 | cyst cell wall glyco-antigen | Rabbit | 100 µg | Datasheet |
| 7642 | cyst cell wall glyco-antigen | Rabbit | 100 µg |
犬ジステンパーウイルスに対するモノクローナル抗体
犬ジステンパーウイルス(Canine Distemper Virus: CDV)は犬や猫、オオカミ、コヨーテなど幅広い種の野生動物・飼育動物に感染します。犬ジステンパーウイルスの感染による症状は全身におよび、呼吸器や消化器系、神経系のシステムに影響します。
犬ジステンパーウイルスは麻疹やムンプスを引き起こすウイルスと関連性があり、エアロゾルや体液を介して高い感染性を示します。特に子犬やワクチン未接種の成犬が感染しやすいです。
Virostat社は犬ジステンパーウイルスのヌクレオカプシドに特異的なモノクローナル抗体のセットを発売しました。IFAやELISAなどの免疫測定法による犬ジステンパーウイルスの検出に、当社の抗体ペアをご利用ください。

| カタログ番号 | 特異性 | 宿主 | 単位 | データシート |
|---|---|---|---|---|
| 7515 | nucleocapsid of CDV | Mouse | 100 µg | Datasheet |
| 7516 | nucleocapsid of CDV | Mouse | 100 µg | |
| 7517 | nucleocapsid of CDV | Mouse | 100 µg |
COVID-19変異株の抗原検出
COVID-19の変異株はスパイクタンパク質の変異によって進化してきました。ほとんどの抗原検出検査は、ウイルスのヌクレオキャプシドを標的とした抗体ペアを使用します。このヌクレオキャプシドはスパイクタンパク質よりも比較的保存されています。
しかし、突然変異はヌクレオキャプシドにも起こります。検出に使用された抗体ペアが突然変異のためにこの抗原に結合しない場合、偽陰性を示す可能性があります。
ViroStat社のCOVID-19モノクローナル抗体はすべて、現在流行している最も一般的な変異体(イギリスB.1.1.7、南アフリカB.1.351、ブラジルP.1)のヌクレオキャプシドとの反応性が検証されています。したがって、これらの抗体で変異株が検出されることを保証します。

| カタログ番号 | 特異性 | 宿主 | 単位 | データシート |
|---|---|---|---|---|
| 3851 | nucleoprotein of SARS & COVID-19 | Mouse | 100 µg | Datasheet1 |
| 3861 | nucleoprotein of SARS & COVID-19 | Mouse | 100 µg | |
| 3862 | nucleoprotein of SARS & COVID-19 | Mouse | 100 µg | |
| 3863 | nucleoprotein of SARS & COVID-19 | Mouse | 100 µg | |
| 3864 | nucleoprotein of SARS & COVID-19 | Mouse | 100 µg | |
| 3865 | nucleocapsid | Mouse | 100 µg | Datasheet2 |
| 3866 | nucleocapsid | Mouse | 100 µg | |
| 3867 | nucleocapsid | Mouse | 100 µg | |
| 3868 | nucleocapsid | Mouse | 100 µg |
グラム陽性菌の検出
グラム陽性菌の迅速な検出が重要とされる病状があります。一つの例に、時間が本質的に重要である敗血症があります。ほとんどのグラム陽性菌は、リポタイコ酸(LTA)の細胞壁ポリマーを有します。LTAは増殖中の細菌から分泌され、また無傷の細菌自体にも存在しています。
ViroStat は、新しい抗LTAモノクローナル抗体をリリースしたばかりです。これらの抗体ペアは、無傷の細菌の細胞壁LTAと分泌LTAの両方を検出できます。

これらの新しい抗体は、多くのグラム陽性細菌のLTAを検出します。(黄色ブドウ球菌、表皮ブドウ球菌、肺炎連鎖球菌、化膿連鎖球菌、セレウス菌、枯草菌、エンテロコッカスフェカリスおよびリステリア種が含まれます。)これらの新しい抗体ペアは細菌検出のアッセイ開発のために、強力なツールとして利用できます。
| カタログ番号 | 特異性 | 宿主 | 単位 | データシート |
|---|---|---|---|---|
| 3801 | lipoteichoic acid | Mouse | 100 µg | Datasheet |
| 3811 | lipoteichoic acid | Mouse | 100 µg | |
| 3802 | lipoteichoic acid | Mouse | 100 µg | |
| 3803 | lipoteichoic acid | Mouse | 100 µg | |
| 3804 | lipoteichoic acid | Mouse | 100 µg |
抗新型コロナウイルスヌクレオカプシド抗体製品のご紹介
新型コロナウイルスのヌクレオカプシドが抗原検出に適切な理由:
1) 感染細胞中で大量に生産されます
2) 高度に保存されたタンパク質であり変異しにくい
感染した細胞の細胞質にはヌクレオカプシド抗原が大量に存在します。 この細胞はNPスワブで収集され、検体バッファーで抗原を抽出することによりイムノアッセイによる検出が可能となります。

ViroStat社は、COVID-19ウイルスのヌクレオカプシドに対する新しいモノクローナル抗体を開発しました。60種類の候補抗体から、ネイティブウイルス抗原を検出するための最高の結合親和性と最高のELISAペアリングを有する5種類の抗体を製品化致しました。 データシート
抗アストロウイルス抗体の取扱いを開始しました。
アストロウイルスは比較的近年に発見されたノンエンベロープウイルスで、ヒトや動物の胃腸炎の原因となります。幼児や高齢者が、未発達な免疫系や衰えた免疫系により最も感染しやすいウイルスです。その症状は嘔吐や下痢を含み、脱水症状になる可能性があります。アストロウイルスは糞便検体のPCRおよび免疫アッセイにて検出されます。Virostat社ではアストロウイルスに対する新しいモノクローナル抗体をリリースしました。これらの抗体はアストロウイルスの主要なカプシドタンパク質を特異的に検出し、抗原検出のためにペア抗体としてご使用いただけます。データシート
各商品の価格のお問合せ、商品仕様書のご依頼、その他のお問い合わせは下記までお願いします。
【商品取扱元】株式会社 東京未来スタイル
info@tokyofuturestyle.com
TEL:029-851-9222 FAX:029-851-9220

商品カタログPDF